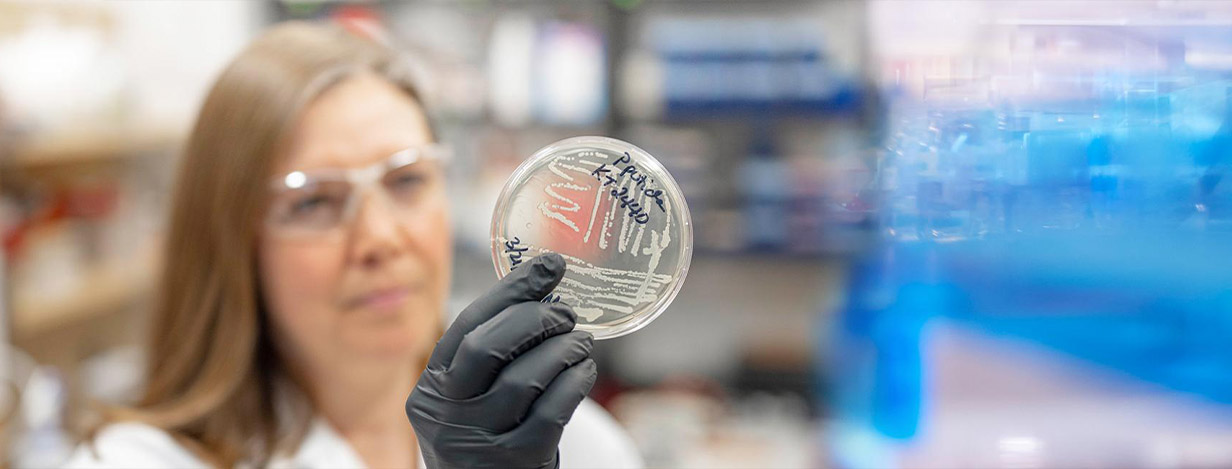

Worcester Polytechnic Institute
Worcester, MA
Worcester, MA
Academics with impact
Worcester Polytechnic Institute (WPI) is not just a place to learn science and engineering; it’s a place to do science and engineering. For students dreaming of a future in medicine, healthcare, or biomedical innovation, WPI offers a hands-on, project-based approach that sets you apart. Here, you won't just memorize textbooks; you'll be rolling up your sleeves and tackling real-world problems from day one.
Academics with impact
At the heart of a WPI education is the revolutionary WPI Plan, which replaces traditional lectures with a dynamic, project-focused curriculum. For aspiring healthcare professionals, this means you can major in a field you're passionate about—like Biomedical Engineering, one of the top programs in the country—while receiving dedicated guidance through the Pre-Health Advising Program. This personalized support ensures you complete all the prerequisites for medical, dental, or veterinary school. The curriculum is designed to build not just your scientific knowledge but also your problem-solving, teamwork, and communication skills—all essential for a successful career in medicine.
A vibrant and collaborative community
Life at WPI is as engaging outside the classroom as it is inside. With over 200 clubs and organizations, there's a place for everyone to find their niche, from academic and professional societies to a thriving arts and culture scene. The campus community is known for its collaborative spirit, a welcome environment where students support each other's success. Located in Worcester, the heart of New England, WPI offers the best of both worlds: a beautiful, self-contained campus and easy access to the rich cultural and recreational opportunities of a vibrant city. This prime location also provides numerous opportunities for internships and research in the area's many biotech and healthcare companies.
Your fast track to a career in health
The Pre-Health Advising Program at WPI is more than just a resource; it's your personalized roadmap to a career in the health professions. At WPI, you won't find a one-size-fits-all "pre-med" major. Instead, you'll work one-on-one with a dedicated pre-health advisor to craft an academic plan that aligns with your passions and the specific requirements of your dream medical, dental, or veterinary program. This tailored approach, combined with WPI's project-based learning, gives you a competitive edge and a portfolio of real-world experience.
 |
WPI is known for strong engineering and science programs with increasing focus on sustainable technologies. |
|
Ranked in the top 5.1% of 20,000 worldwide universities | Center for World University Rankings, 2024 |
|
|
Ranked #12 among the "Top Game Design Programs" for undergraduates | The Princeton Review, 2025 |
|
|
Named a "Best Value College" | The Princeton Review, 2025 |
|
|
Ranked #13 among private schools for "Best Career Placement" | The Princeton Review, 2025 |






"Overall, my collective experiences with projects at WPI have revealed and prepared me for the challenges and rewards of real-life work in a powerful, firsthand way."
“Through project work, I have learned to look critically at problems I don’t necessarily have the answer to. I’ve also gotten better at communicating my ideas through both writing and speaking."
“The project-based curriculum has given me the opportunity to gain valuable experience solving real-life problems. Overall, I feel like I am part of a supportive community of people here at WPI who all have the same goal of changing the world."
“The way it changed my view of the world translates to multiple, different areas of my life. I look at my community as a much smaller piece of a larger world than I used to. I see diversity in a different way.”